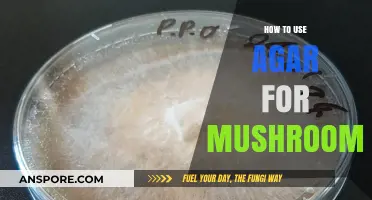
Mastering Mushroom Cultivation: A Guide to Using Agar Effectively

A mushroom keychain pipe is a compact, discreet, and portable smoking accessory designed for on-the-go use. To use it, first ensure the pipe is clean and free of debris. Attach the keychain to your keys or bag for easy access. When ready to use, remove the lid or cap to expose the bowl, pack it lightly with your desired smoking material, and ignite it while inhaling through the mouthpiece. After use, extinguish any remaining embers, clean the bowl, and reattach the lid to prevent odor or spillage. Its small size and whimsical mushroom design make it both functional and stylish, perfect for those who value convenience and discretion.
| Characteristics | Values |
|---|---|
| Material | Typically made of metal, glass, or ceramic. |
| Size | Compact, usually 2-4 inches in length for portability. |
| Design | Shaped like a mushroom with a hollow stem and cap for aesthetic appeal. |
| Functionality | Dual-purpose: serves as a keychain and a smoking pipe. |
| Usage Steps | 1. Remove the keychain from your keys. |
| 2. Pack the bowl (stem base) with a small amount of smoking material. | |
| 3. Light the material while inhaling from the mouthpiece (mushroom cap). | |
| 4. Exhale and repeat as desired. | |
| Cleaning | Use a small brush or pipe cleaner to remove residue after use. |
| Portability | Easy to carry due to its small size and keychain attachment. |
| Discretion | Discrete design allows it to blend in as a regular keychain. |
| Durability | Depends on material; metal and ceramic are more durable than glass. |
| Legal Considerations | Check local laws regarding smoking accessories and their usage. |
| Maintenance | Regular cleaning ensures longevity and better smoking experience. |
| Aesthetic Appeal | Unique mushroom design adds a decorative element to keychains. |
Explore related products
$6.49
What You'll Learn
- Preparation: Clean the pipe, ensure it’s dry, and check for any blockages before first use
- Packing: Grind herbs finely, lightly pack the bowl, avoiding overfilling for smooth airflow
- Lighting: Hold flame to bowl, inhale slowly while lighting to ensure even burn
- Cleaning: Use pipe cleaners or cotton swabs with isopropyl alcohol to remove residue
- Storage: Keep in a cool, dry place, away from direct sunlight or moisture

Preparation: Clean the pipe, ensure it’s dry, and check for any blockages before first use
Before using your mushroom keychain pipe for the first time, proper preparation is crucial to ensure a clean, safe, and enjoyable experience. Start by thoroughly cleaning the pipe, even if it appears new. Residual manufacturing debris, dust, or contaminants can compromise the flavor and hygiene of your session. Use a small brush or pipe cleaner to scrub the interior, and rinse with warm water. For a deeper clean, soak the pipe in isopropyl alcohol (70% concentration) for 30 minutes, then rinse and let it air dry completely.
Once cleaned, drying the pipe is equally important. Moisture trapped inside can lead to mold growth or affect the burn quality. Pat the exterior dry with a clean cloth, then allow the pipe to air dry for at least 24 hours in a well-ventilated area. If time is limited, use a hairdryer on low heat, but avoid excessive warmth, as it may damage the material. Ensure no water remains in the bowl or stem before proceeding.
Checking for blockages is the final step in preparation. Hold the pipe up to a light source and inspect the airway for obstructions. Use a thin tool, like a paperclip or pipe cleaner, to clear any debris gently. A blocked airway can restrict airflow, making the pipe difficult to use and potentially causing uneven burns. This step is particularly important in keychain pipes, which often have compact designs prone to clogging.
By meticulously cleaning, drying, and inspecting your mushroom keychain pipe, you not only enhance its functionality but also prioritize your health. Proper preparation ensures a smooth draw, preserves the pipe’s longevity, and eliminates potential hazards. Treat this step as a ritual—a small investment of time that pays off in every session.
Exploring the Surprising Side Effects of Mushroom Consumption
You may want to see also

Packing: Grind herbs finely, lightly pack the bowl, avoiding overfilling for smooth airflow
The art of packing a mushroom keychain pipe begins with the grind. Herbs should be reduced to a fine, even consistency, akin to coarse sand. This uniformity ensures an even burn and maximizes the surface area for efficient combustion. A four-piece grinder with a kief catcher is ideal, as it separates the finer particles for later use, but a simple two-piece grinder or even a sharp knife will suffice in a pinch. The goal is to eliminate large chunks that can restrict airflow or burn unevenly.
Once ground, the packing process demands a delicate touch. Lightly sprinkle the herbs into the bowl, using a small tool or your fingertips to gently tamp them down. Aim for a density that allows air to pass through without resistance—imagine packing brown sugar for baking. Overfilling the bowl is a common mistake that leads to harsh, uneven draws and wasted material. A properly packed bowl should be about three-quarters full, leaving enough space for air to circulate and the herbs to expand as they burn.
The science behind this technique lies in airflow dynamics. A loosely packed bowl allows too much oxygen, causing the herbs to burn quickly and unevenly, while an overpacked bowl restricts oxygen, resulting in a labored draw and incomplete combustion. The sweet spot lies in balance, where the herbs are compact enough to stay lit but loose enough to allow smooth, effortless inhalation. This principle applies whether you’re using a mushroom keychain pipe or any other smoking device.
Practical tips can elevate your packing game. If you’re using a particularly dense herb, consider mixing in a small amount of finely ground material to improve airflow. For those who prefer a cooler, smoother hit, place a small screen at the bottom of the bowl to prevent ash and debris from being drawn through. Additionally, if you’re sharing the pipe, ensure each pack is consistent to maintain a uniform experience for all users.
In conclusion, mastering the packing technique for a mushroom keychain pipe is both an art and a science. It requires attention to detail, from the grind to the final tap of the bowl. By focusing on fineness, lightness, and airflow, you can ensure a smooth, enjoyable experience every time. Remember, the goal isn’t just to smoke—it’s to savor the moment with precision and care.
Does Little Caesars Use Shiitake Mushrooms? Ingredients Unveiled
You may want to see also

Lighting: Hold flame to bowl, inhale slowly while lighting to ensure even burn
The delicate art of lighting a mushroom keychain pipe hinges on precision and timing. Unlike larger pipes, the diminutive bowl demands a focused flame and deliberate inhalation to achieve an even burn. A lighter with a narrow, adjustable flame is ideal, allowing you to target the bowl's center without scorching the surrounding material.
Hold the flame directly above the bowl, hovering just above the rim. This proximity ensures the heat is concentrated where it's needed most. As you apply the flame, begin to inhale slowly and steadily through the mouthpiece. This simultaneous action draws the flame down into the bowl, igniting the contents evenly. Think of it as a controlled dance, where the flame and air work in tandem to create a smooth, consistent burn.
Rushing this step often leads to uneven combustion, resulting in a harsh, uneven draw. Inhaling too quickly can also pull the flame too far down, potentially scorching the bowl and tainting the flavor. Conversely, inhaling too slowly may not draw enough heat, leaving unburned material and wasting your substance. Finding the right rhythm takes practice, but the reward is a clean, flavorful hit that maximizes the potential of your mushroom keychain pipe.
Remember, the goal is not to inhale deeply, but to create a gentle suction that guides the flame and smoke through the pipe. A slow, steady draw of 2-3 seconds is usually sufficient to achieve a complete burn. With practice, you'll develop a feel for the optimal timing and pressure needed for your specific pipe and preferred material.
For those new to using a mushroom keychain pipe, it can be helpful to start with a smaller amount of material in the bowl. This allows for better control over the burn and reduces the risk of overheating. As you become more comfortable with the technique, you can gradually increase the quantity. Additionally, consider using a screen in the bowl to prevent ash and debris from being drawn through the pipe. This not only improves the overall experience but also makes cleaning easier. With patience and attention to detail, mastering the lighting technique will elevate your enjoyment of this unique and portable smoking accessory.
Did AA's Founder Use Psilocybin Mushrooms for Sobriety?
You may want to see also
Explore related products
$4.49

Cleaning: Use pipe cleaners or cotton swabs with isopropyl alcohol to remove residue
Residue buildup in a mushroom keychain pipe can compromise both flavor and airflow, making regular cleaning essential. Pipe cleaners or cotton swabs paired with isopropyl alcohol are the most effective tools for this task. The alcohol’s solvent properties dissolve tar and resin, while the narrow shape of the cleaners or swabs allows access to tight spaces. For best results, use 91% isopropyl alcohol, as its higher concentration works faster than the 70% variety, which contains more water and evaporates slower.
Begin by disassembling the pipe if possible, separating the bowl, stem, and mouthpiece. Dip a pipe cleaner or cotton swab into the isopropyl alcohol, ensuring it’s damp but not dripping. Insert it into the stem and gently twist back and forth to loosen residue. For stubborn buildup, let the swab or cleaner sit in the affected area for 1–2 minutes before scrubbing. Repeat this process until the cleaner emerges free of debris. For the bowl, use a cotton swab to scrub the interior, paying attention to the edges where resin tends to accumulate.
While cleaning, avoid submerging the entire pipe in alcohol, as this can damage certain materials like wood or painted surfaces. Instead, focus on targeted application. After cleaning, rinse the pipe with warm water to remove any alcohol residue, then allow it to air dry completely before use. This ensures no chemical aftertaste remains. For deep cleaning, consider soaking removable parts in a small container of isopropyl alcohol for 30 minutes, followed by a thorough rinse.
Regular maintenance prevents the need for aggressive cleaning sessions. Wipe down the pipe after each use with a dry cloth to minimize buildup. For daily users, a full cleaning with isopropyl alcohol should be performed weekly. Occasional users can extend this to every 2–3 weeks. Proper care not only preserves the pipe’s functionality but also enhances the overall experience by ensuring each session is as smooth as the first.
Comparatively, while other cleaning methods like salt and rubbing alcohol or vinegar solutions exist, isopropyl alcohol with pipe cleaners or cotton swabs remains the most efficient and accessible option. Its simplicity and effectiveness make it the go-to choice for both novice and experienced users. By incorporating this routine into your pipe care, you’ll maintain optimal performance and extend the lifespan of your mushroom keychain pipe.
Avoid Mushroom Compost: Why It Harms Your Worm Farm Ecosystem
You may want to see also

Storage: Keep in a cool, dry place, away from direct sunlight or moisture
Proper storage of your mushroom keychain pipe is crucial for maintaining its functionality and longevity. Exposure to heat, moisture, or direct sunlight can degrade the material, warp its shape, or promote mold growth, rendering it unusable. Always store it in a cool, dry environment, such as a drawer, cabinet, or airtight container. Avoid leaving it in a car, near a heater, or in a humid bathroom, as these conditions accelerate deterioration.
Consider the material of your pipe when choosing a storage location. Glass or ceramic pipes are particularly susceptible to temperature fluctuations, while metal or silicone options may tolerate slightly warmer conditions. However, the "cool, dry place" rule remains universal. For added protection, wrap the pipe in a soft cloth or keep it in a padded pouch to prevent scratches or cracks during storage.
Moisture is the silent enemy of any smoking accessory, including your mushroom keychain pipe. Residual moisture can lead to mildew, unpleasant odors, or clogs in the airway. After each use, ensure the pipe is thoroughly cleaned and completely dry before storing. Silica gel packets placed in the storage container can help absorb ambient moisture, keeping the environment dry and safe for your pipe.
Direct sunlight poses another threat, especially for colored or painted pipes. UV rays can fade vibrant designs or weaken certain materials over time. Store your pipe in a dark space, like a closed drawer or opaque container, to shield it from light exposure. This simple step preserves both the aesthetic appeal and structural integrity of your keychain pipe.
Finally, think of storage as part of your maintenance routine. Just as you clean your pipe regularly, designate a specific spot for it when not in use. Consistency in storage practices ensures your mushroom keychain pipe remains ready for use whenever you need it. By prioritizing a cool, dry environment and avoiding sunlight or moisture, you’ll extend its lifespan and enjoy a better experience every time.
Did Plato's Philosophy Include Psychedelic Mushrooms? Exploring Ancient Secrets
You may want to see also
Frequently asked questions
Unscrew the top of the mushroom cap to reveal the bowl. Gently pack a small amount of finely ground smoking material into the bowl, ensuring it’s not too tight or too loose for optimal airflow.
Disassemble the pipe by unscrewing the mushroom cap and stem. Use a small cleaning brush or pipe cleaner to remove residue from the bowl and stem. For deeper cleaning, soak the parts in isopropyl alcohol and rinse thoroughly before reassembling.
Yes, the mushroom keychain pipe is designed to be compact and discreet, resembling a regular keychain. Its small size and unique design make it easy to carry in your pocket, purse, or attached to your keys.
After packing the bowl, place your lips on the stem and light the material in the bowl while inhaling slowly. The smoke will travel through the stem and into your mouth. Be cautious as the pipe may get hot during use.